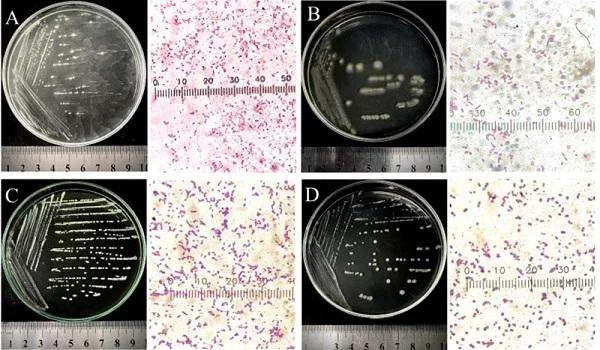
Hướng Dẫn Chi Tiết về Phân Lập Vi Khuẩn Hấp Thu Sulfide từ Nước Thải Thủy Sản

CECC "Thúc Giục" Mỹ Nhanh Chóng Giải Quyết Vấn Đề Nhập Khẩu Thủy Sản Trung Quốc
CECC và Vấn Đề Nhập Khẩu Thủy Sản Trung Quốc
CECC (Ủy ban Chống Đánh Giá Nhóm Ở Đài Loan) là tổ chức chính phủ của Đài Loan, chịu trách nhiệm đối phó với các vấn đề về an ninh, kinh tế và xã hội.
Vấn Đề Nhập Khẩu Thủy Sản Trung Quốc:
Trung Quốc, một trong những quốc gia sản xuất thủy sản lớn nhất thế giới, đang gặp phải nhiều lo ngại về an toàn thực phẩm và tuân thủ quy định thị trường quốc tế.
Lý Do và Yêu Cầu của CECC
An Toàn Thực Phẩm:
CECC đặt ra nghi vấn về an toàn của các sản phẩm thủy sản nhập khẩu từ Trung Quốc, bao gồm cả việc sử dụng hóa chất và chất phụ gia không an toàn cho sức khỏe.
Quản Lý Thị Trường:
CECC yêu cầu Mỹ phải nhanh chóng thực hiện các biện pháp cần thiết để đảm bảo rằng các sản phẩm thủy sản nhập khẩu từ Trung Quốc tuân thủ các quy định và tiêu chuẩn chất lượng.
Biện Pháp Đề Xuất và Hậu Quả Của CECC
Biện Pháp Đề Xuất:
CECC đề xuất việc tăng cường kiểm tra và giám sát các sản phẩm thủy sản nhập khẩu từ Trung Quốc để đảm bảo an toàn thực phẩm và tuân thủ quy định.
Hậu Quả Của Việc Không Giải Quyết Vấn Đề:
Nếu Mỹ không xử lý nhanh chóng vấn đề này, có thể gây nguy cơ cho sức khỏe của người tiêu dùng và gây ảnh hưởng tiêu cực đến thị trường thủy sản.
Tác Động và Ý Nghĩa Của Yêu Cầu Của CECC
Tác Động Đến An Toàn Thực Phẩm:
Việc giải quyết vấn đề nhập khẩu thủy sản từ Trung Quốc có thể cải thiện an toàn thực phẩm và bảo vệ sức khỏe của người tiêu dùng.
Ý Nghĩa Trong Quản Lý Thị Trường:
Yêu cầu của CECC cũng nhấn mạnh về ý nghĩa quản lý thị trường, đảm bảo rằng các sản phẩm nhập khẩu tuân thủ quy định và tiêu chuẩn chất lượng.
Đối Sánh Với Quy Định và Thực Tiễn Quốc Tế
So Sánh Với Quy Định Quốc Tế:
CECC đề xuất các biện pháp tương tự với các quy định quốc tế về an toàn thực phẩm và quản lý thị trường, như của Liên minh Châu Âu và Hoa Kỳ.
Hợp Tác Quốc Tế:
Việc giải quyết vấn đề này cũng tạo điều kiện cho sự hợp tác quốc tế trong việc đảm bảo an toàn thực phẩm và quản lý thị trường toàn cầu.
Kết Luận và Triển Vọng
Kết Luận:
Yêu cầu của CECC đề cao vấn đề an toàn thực phẩm và quản lý thị trường, nhấn mạnh về tầm quan trọng của việc giải quyết vấn đề nhập khẩu thủy sản từ Trung Quốc.
Triển Vọng:
Hy vọng rằng việc Mỹ và các quốc gia khác sẽ cùng nhau tìm ra giải pháp hiệu quả để đảm bảo an toàn thực phẩm và quản lý thị trường trong ngành công nghiệp thủy sản toàn cầu.